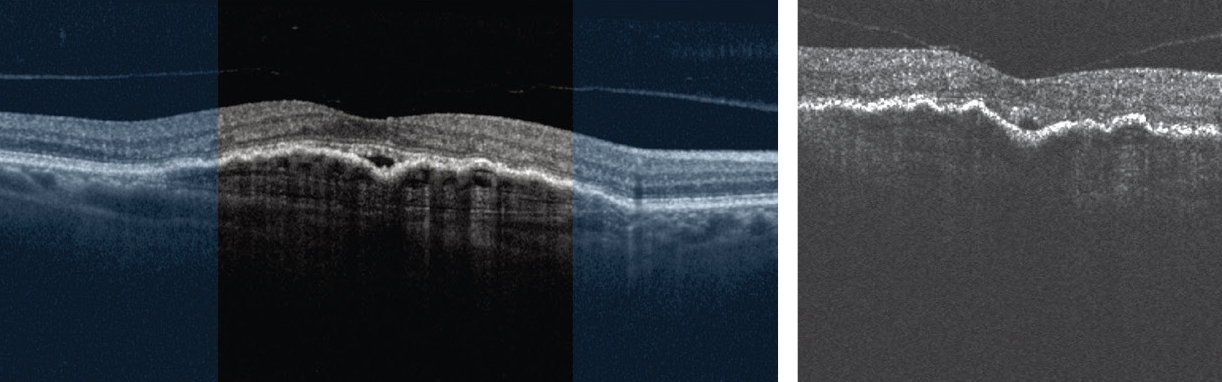

| New Insights in Imaging |
Take-home points
|
 |
|
Bios DISCLOSURE: Dr. Holekamp |
Home-based, patient-operated optical coherence tomography seems to be not only feasible, but the typical patient with age-related macular degeneration can obtain high-quality scans, results of a pilot study showed.1
The recent study essentially proves that you can drop ship an OCT device to someone’s home. They can take it out of the box and set it up themselves. They can self-image, producing very high-quality scans of the central macula. Those images can be successfully uploaded to the cloud, and doctors can, from a laptop, access those images to review them—and the images are of sufficient quality that they can also be analyzed by artificial intelligence.
What’s noteworthy is that these are all AMD patients. Their median age was 75 years, a group that’s thought not to be savvy with technology. This shows that the device really is simple and straightforward to use.
Study design and results
The Home OCT Performance Study was a feasibility study of 15 patients who obtained on average 5.7 (±0.9) scans per week over three months. The study was conducted from December 2020 to August 2021. After a baseline OCT was obtained in the office, participants were sent the Notal Vision Home OCT device and a printed detailed guide via courier—the first time they got to see the device.
All 15 patients completed the study. Ninety-five percent of the scans were obtained successfully. Among all the acquired scans, an average of 76 scans, or 93 percent, were eligible for fluid grading analysis by the Notal OCT Analyzer or NOA (Figure). The study used a manufacturer signal quality index (MSI) to quantify image quality. The average MSI among all home-acquired scans was 4.5 (±1.1), and 97 (±6) percent of scans had MSI >2, the recommended threshold for satisfactory imaging. Over the course of the study, the duration of the self-imaging sessions decreased from a median of 45.4 to 38 seconds to scan a single eye.
We also know from the study that there was a positive patient experience. Patients took a survey at the conclusion, and they gave it high marks. That resonates with my own experience. I now have had approximately 20 patients on this device through my experience in early phase clinical trials and patients love it.
In our study, the cutoff for vision was 20/200, but we also found out that patients with vision as poor as 20/320 can image themselves.
|
| Image quality comparison of in-office Heidelberg Engineering Spectralis optical coherence tomography scan (left) and patient-operated unsupervised, at-home self-imaging with Notal Home OCT (right and below). |
Future studies
 |
A second study is underway. The goal is to demonstrate that the quality of scan is clinically equivalent to what we can obtain in the office. If that study proves to be positive, it could lead to Food and Drug Administration approval. Then I think the next step would be to have studies showing that the Home OCT can reliably decrease the treatment burden or the visit burden.
A key to acceptance of this technology will be physicians’ willingness to change their current treatment paradigm. Change is always difficult, but if physicians can learn to trust a validated, highly sophisticated device, then patients can image themselves at home.
The physician can go to the cloud and look at the image and also set thresholds for retinal fluid. If the patient’s OCT exceeds those thresholds, an alert can notify the physician that the patient needs a treatment, and the patient just comes in for a shot. It’s possible that the patient wouldn’t even need an OCT in the office that day because an OCT was obtained at home, and the physician has access to it.
It’s also possible that the patient wouldn’t have to be on a fixed-interval dosing or even a treat-and-extend regimen, as we currently use. The patient could just come in whenever their fluid reaches the treatment threshold set by the physician.
Potential for home-based OCT
 |
This would be a real change in the treatment paradigm. It could allow for more individualization of treatment, for a lower utilization of resources, and it could ideally cut health-care costs—not only the direct costs of monitoring in the office, but the indirect costs of patients coming to the office, driving several hours, having a family member or caregiver take off work. There are many indirect costs associated with the heavy visit burden and monitoring burden of AMD.
We’ve learned so much about nAMD by performing OCT daily on patients receiving anti-VEGF therapy. We’ve learned that there’s a wide variety of treatment response and reaccumulation of fluid. We’ve learned about differences between fluid compartments and how they present in patients, such as subretinal fluid and intraretinal fluid.
In our current practice, we’re getting an OCT at day one and day 28, but with Home OCT we can fill in all the other days. We’re learning a lot more about this disease than we ever knew before because we have a new way of collecting additional data.
And Home OCT will likely be useful for any retinal disease in which fluid needs to be monitored. The future could include use for diabetes and diabetic macular edema and retinal vascular occlusive disease. So, it has the potential to be a very important and useful research tool. RS
REFERENCE
1. Liu Y, Holekamp NLM, Heier JS. Prospective, longitudinal study: Daily self-imaging with home OCT in neovascular age-related macular degeneration. Ophthalmol Ret. 2022: doi.org/10.1016/j.oret.2022.02.011.



